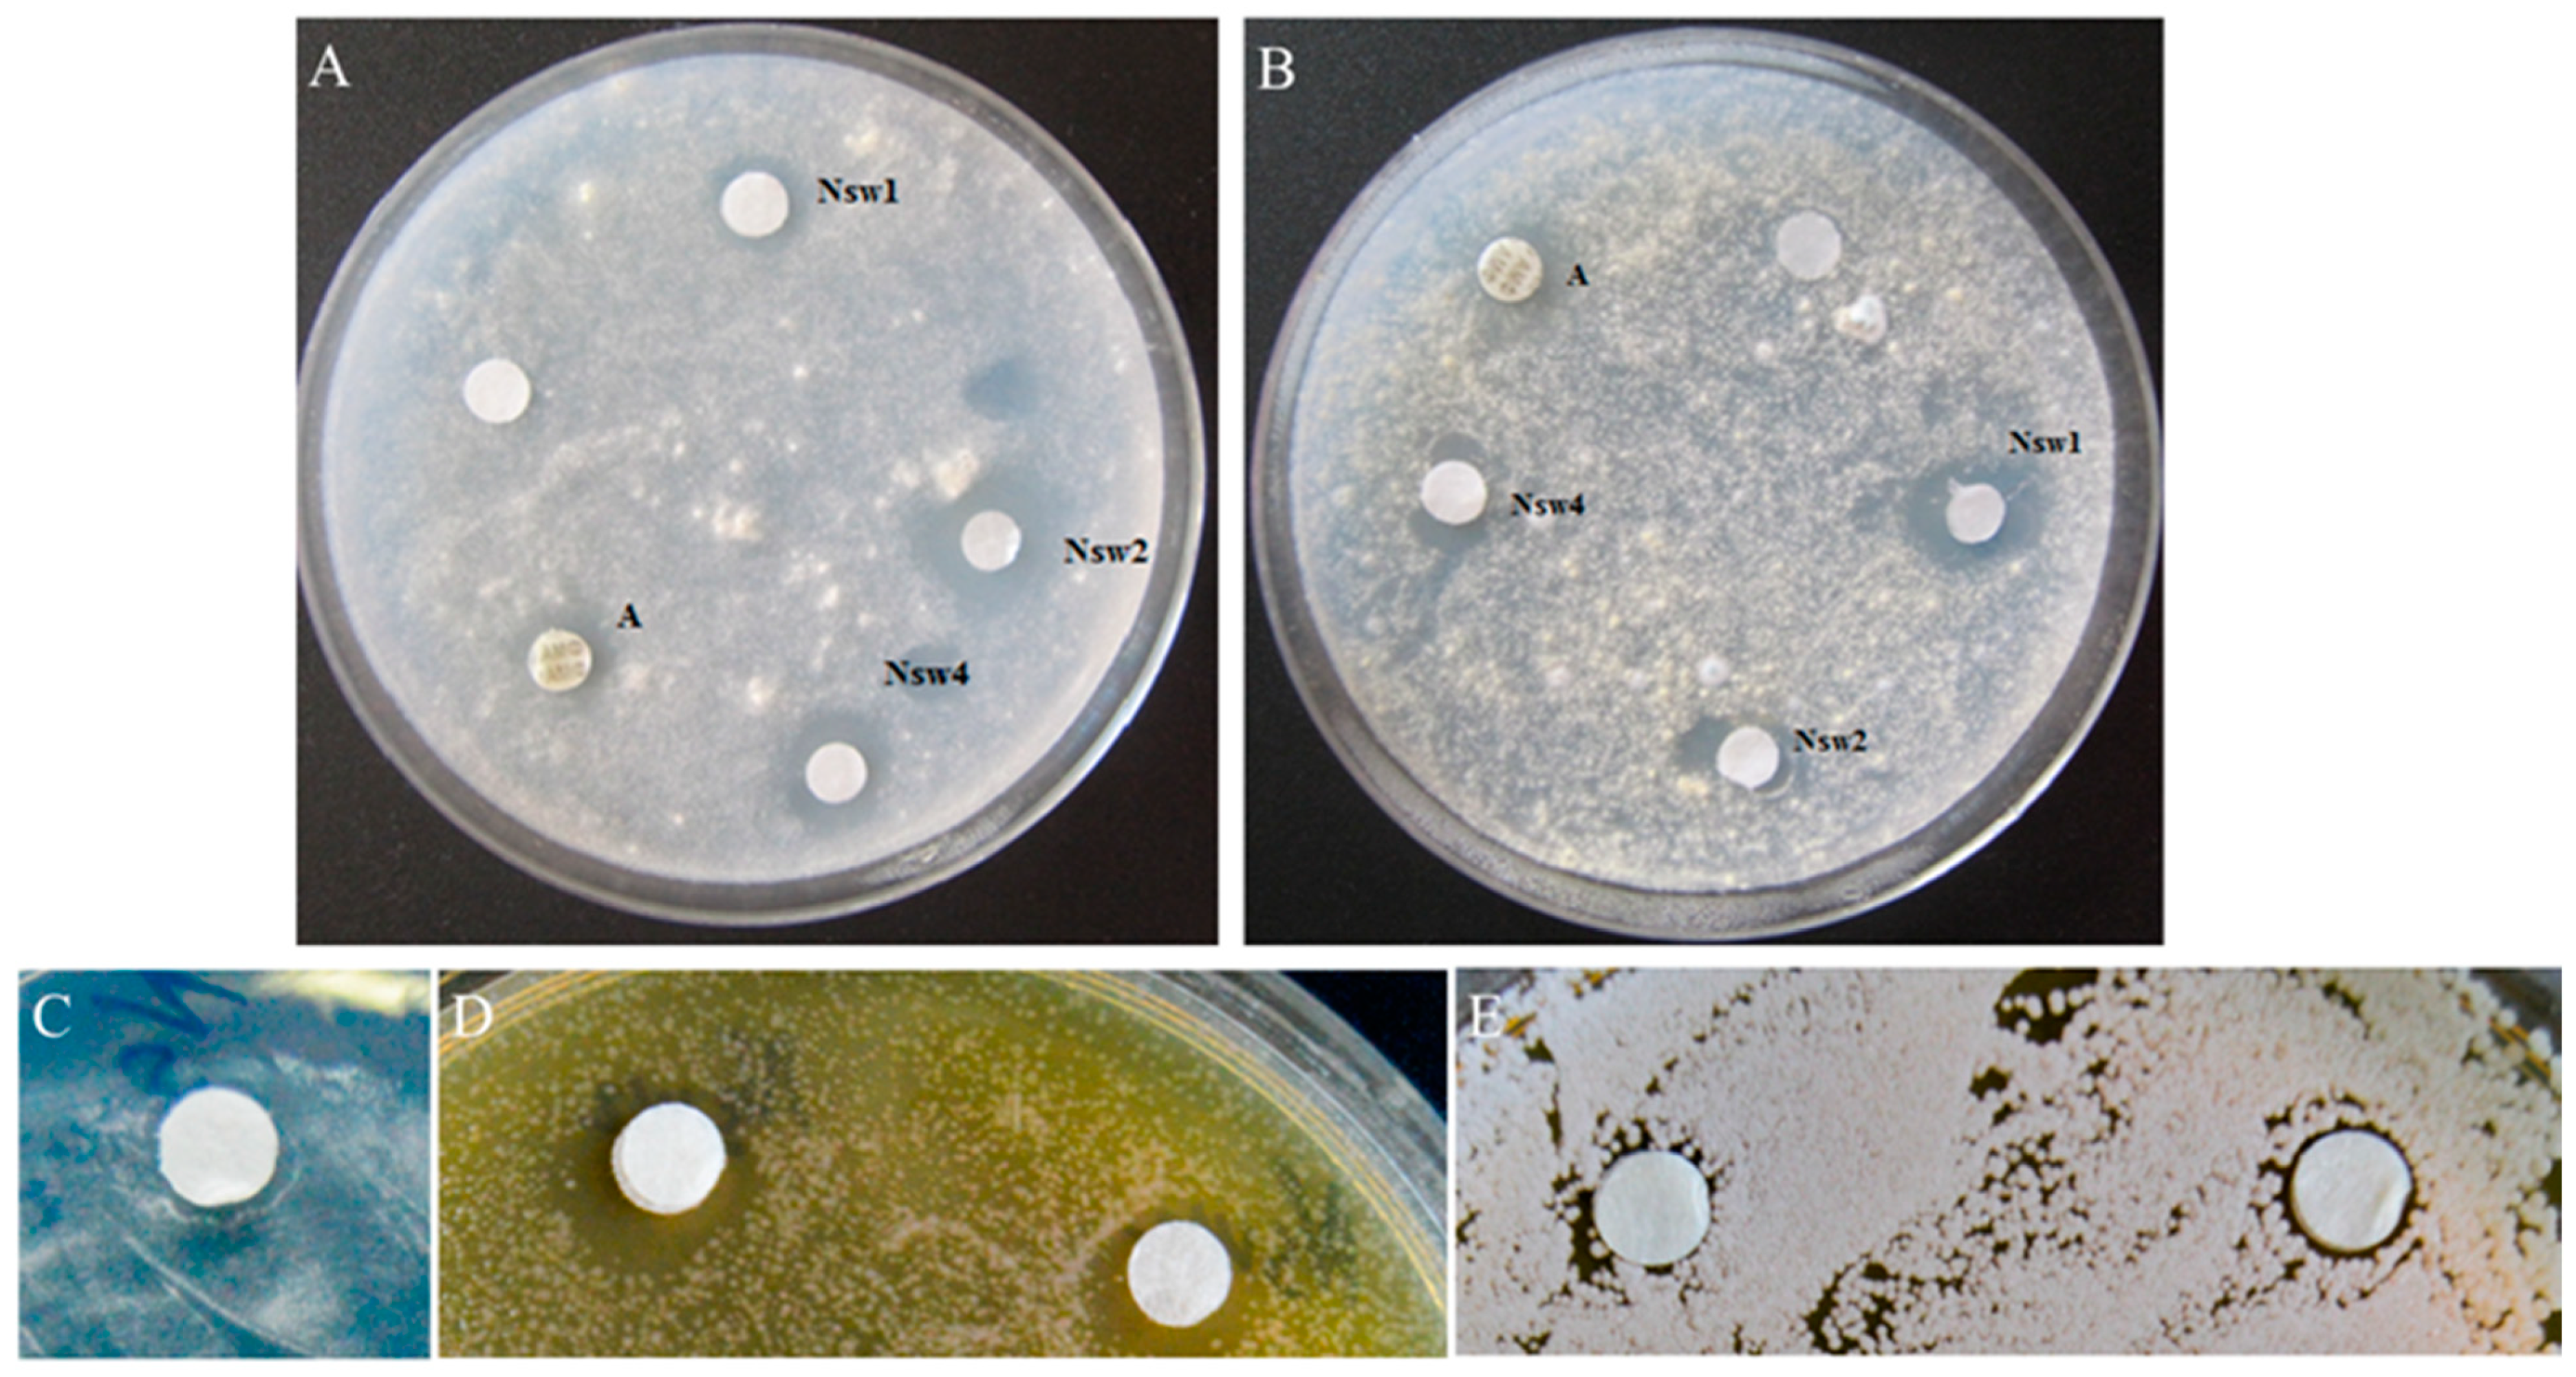
Antibiotics 10 00166 g003

Nigellothionins from Black Cumin (Nigella sativa L.) Seeds Demonstrate Strong Antifungal and Cytotoxic Activity
Abstract
:1. Introduction
2. Results
2.1. A New Subfamily of the Antimicrobial Peptides Isolated from N. sativa Seeds Is Represented by Plant Thionins with 8-Cys Motif (Thionin I Class)
2.2. Thionins from N. sativa Seeds Demonstrate Growth Inhibitory Activity against Filamentous Fungi and Yeasts
2.3. Cytotoxic Activity Caused by the NsW2 Thionin from N. sativa towards Tumor and Normal Cell Lines In Vitro
3. Discussion
4. Materials and Methods
4.1. Microorganisms
4.1.1. Non-Clinical Strains
4.1.2. Clinical Isolates
4.2. Isolation of the Thionins from Black Cumin (Nigella sativa) and Structural Studies
4.2.1. Thionins Isolation Procedure
4.2.2. Determination of Peptides Purity
4.2.3. Peptide Concentration Measurements
4.2.4. LC/ESI-MS Analysis
4.2.5. Reduction and Alkylation
4.2.6. Edman Sequencing
4.3. Biological Activity
4.3.1. Antifungal Activity
4.3.2. MIC Determination
4.3.3. Cytotoxic Activity
4.3.4. Testing on Heterochromatin Condensation in Human Buccal Epithelium Cells
5. Statistical Analysis
6. Conclusions
Supplementary Materials
Author Contributions
Funding
Institutional Review Board Statement
Informed Consent Statement
Acknowledgments
Conflicts of Interest
References
- Campos, M.L.; De Souza, C.M.; De Oliveira, K.B.S.; Dias, S.C.; Franco, O.L. The role of antimicrobial peptides in plant immunity. J. Exp. Bot. 2018, 69, 4997–5011. [Google Scholar] [CrossRef] [PubMed] [Green Version]
- Tam, J.P.; Wang, S.; Wong, K.H.; Tan, W.L. Antimicrobial peptides from plants. Pharmaceuticals 2015, 8, 711–757. [Google Scholar] [CrossRef]
- García-Olmedo, F.; Molina, A.; Alamillo, J.M.; Rodriguez-Palenzuéla, P. Plant defense peptides. Biopolymers 1998, 47, 479–491. [Google Scholar] [CrossRef]
- Okada, T.; Yoshizumi, H.; Terashima, Y. A Lethal Toxic Substance for Brewing Yeast in Wheat and Barley: Part I. Assay of Toxicity on Various Grains, and Sensitivity Of Various Yeast Strains. Agric. Biol. Chem. 1970, 34, 1084–1088. [Google Scholar] [CrossRef]
- Stec, B. Plant thionins—The structural perspective. Cell. Mol. Life Sci. 2006, 63, 1370–1385. [Google Scholar] [CrossRef] [PubMed]
- Clore, G.M.; Nilges, M.; Sukumaran, D.K.; Brünger, A.T.; Karplus, M.; Gronenborn, A.M. The three-dimensional structure of α1-purothionin in solution: Combined use of nuclear magnetic resonance, distance geometry and restrained molecular dynamics. EMBO J. 1986, 5, 2729. [Google Scholar] [CrossRef] [PubMed]
- Teeter, M.M.; Mazer, J.A.; L’ltalien, J.J. Primary Structure of the Hydrophobic Plant Protein Crambin. Biochemistry 1981, 20, 5437–5443. [Google Scholar] [CrossRef]
- Vila-Perelló, M.; Sánchez-Vallet, A.; García-Olmedo, F.; Molina, A.; Andreu, D. Synthetic and structural studies on Pyrularia pubera thionin: A single-residue mutation enhances activity against Gram-negative bacteria. FEBS Lett. 2003, 536, 215–219. [Google Scholar] [CrossRef] [Green Version]
- Llanos, P.; Henriquez, M.; Minic, J.; Elmorjani, K.; Marion, D.; Riquelme, G.; Molgo, J.; Benoit, E. Puroindoline-a and alpha1-purothionin form ion channels in giant liposomes but exert different toxic actions on murine cells. FEBS J. 2006, 273, 1710–1722. [Google Scholar] [CrossRef] [PubMed]
- Johansson, S.; Gullbo, J.; Lindholm, P.; Ek, B.; Thunberg, E.; Samuelsson, G.; Larsson, R.; Bohlin, L.; Claeson, P. Small, novel proteins from the mistletoe Phoradendron tomentosum exhibit highly selective cytotoxicity to human breast cancer cells. Cell. Mol. Life Sci. 2003, 60, 165–175. [Google Scholar] [CrossRef] [PubMed]
- Vasilchenko, A.S.; Smirnov, A.N.; Zavriev, S.K.; Grishin, E.V.; Vasilchenko, A.V.; Rogozhin, E.A. Novel Thionins from Black Seed (Nigella sativa L.) Demonstrate Antimicrobial Activity. Int. J. Pept. Res. Ther. 2017, 23, 171–180. [Google Scholar] [CrossRef]
- Ali, S.; Ganai, B.A.; Kamili, A.N.; Bhat, A.A.; Mir, Z.A.; Bhat, J.A.; Tyagi, A.; Islam, S.T.; Mushtaq, M.; Yadav, P.; et al. Pathogenesis-related proteins and peptides as promising tools for engineering plants with multiple stress tolerance. Microbiol. Res. 2018, 212–213, 29–37. [Google Scholar] [CrossRef]
- Odintsova, T.I.; Slezina, M.P.; Istomina, E.A. Plant thionins: Structure, biological functions and potential use in biotechnology. Vavilovskii Zhurnal Genet. Selektsii 2018, 22, 667–675. [Google Scholar] [CrossRef] [Green Version]
- Bunge, S.; Wolters, J.; Apel, K. A comparison of leaf thionin sequences of barley cultivars and wild barley species. MGG Mol. Gen. Genet. 1992, 231, 460–468. [Google Scholar] [CrossRef] [PubMed]
- Schrader-Fischer, G.; Apel, K. cDNA-derived identification of novel thionin precursors in Viscum album that contain highly divergent thionin domains but conserved signal and acidic polypeptide domains. Plant Mol. Biol. 1993, 23, 1233–1242. [Google Scholar] [CrossRef] [PubMed]
- Ponz, F.; Paz-Ares, J.; Hernández-Lucas, C.; García-Olmedo, F.; Carbonero, P. Cloning and nucleotide sequence of a cDNA encoding the precursor of the barley toxin α-hordothionin. Eur. J. Biochem. 1986, 156, 131–135. [Google Scholar] [CrossRef] [PubMed] [Green Version]
- Castagnaro, A.; Maraña, C.; Carbonero, P.; García-Olmedo, F. cDNA cloning and nucleotide sequences of alpha 1 and alpha 2 thionins from hexaploid wheat endosperm. Plant Physiol. 1994, 106, 1221–1222. [Google Scholar] [CrossRef] [PubMed] [Green Version]
- Milbradt, A.G.; Kerek, F.; Moroder, L.; Renner, C. Structural characterization of hellethionins from Helleborus purpurascens. Biochemistry 2003, 42, 2404–2411. [Google Scholar] [CrossRef] [PubMed]
- Stec, B.; Rao, U.; Teeter, M.M. Refinement of purothionins reveals solute particles important for lattice formation and toxicity. Part 2: Structure of beta-purothionin at 1.7 Angstrom resolution. Acta Crystallogr. Sect. D Biol. Crystallogr. 1995, 51, 914–924. [Google Scholar] [CrossRef]
- Vahedi Shahandashti, R.; Lass-Flörl, C. Antifungal resistance in Aspergillus terreus: A current scenario. Fungal Genet. Biol. 2019, 131, 103247. [Google Scholar] [CrossRef]
- Oard, S.V. Deciphering a mechanism of membrane permeabilization by α-hordothionin peptide. Biochim. Biophys. Acta Biomembr. 2011, 1808, 1737–1745. [Google Scholar] [CrossRef] [Green Version]
- Çakir, B.; Gülseren, İ. Identification of Novel Proteins from Black Cumin Seed Meals Based on 2D Gel Electrophoresis and MALDI-TOF/TOF-MS Analysis. Plant Foods Hum. Nutr. 2019, 74, 414–420. [Google Scholar] [CrossRef] [PubMed]
- Rogozhin, E.A.; Oshchepkova, Y.I.; Odintsova, T.I.; Khadeeva, N.V.; Veshkurova, O.N.; Egorov, T.A.; Grishin, E.V.; Salikhov, S.I. Novel antifungal defensins from Nigella sativa L. seeds. Plant Physiol. Biochem. 2011, 49, 131–137. [Google Scholar] [CrossRef] [PubMed]
- Oshchepkova, Y.I.; Veshkurova, O.N.; Rogozhin, E.A.; Musolyamov, A.K.; Smirnov, A.N.; Odintsova, T.I.; Egorov, T.A.; Grishin, E.V.; Salikhov, S.I. Isolation of the lipid-transporting protein Ns-LTP1 from seeds of the garden fennel flower (Nigella sativa). Russ. J. Bioorganic Chem. 2009, 35, 315–319. [Google Scholar] [CrossRef]
- Rogozhin, E.A.; Sadykova, V.S.; Baranova, A.A.; Vasilchenko, A.S.; Lushpa, V.A.; Mineev, K.S.; Georgieva, M.L.; Kul’ko, A.B.; Krasheninnikov, M.E.; Lyundup, A.V.; et al. A novel lipopeptaibol emericellipsin a with antimicrobial and antitumor activity produced by the extremophilic fungus emericellopsis alkalina. Molecules 2018, 23, 2785. [Google Scholar] [CrossRef] [Green Version]
- Orril, S.; Scalonis, A.; Urechs, K.; Pucci, P.; Schaller, G. Amino Acid Sequence, SS Bridge Arrangement and Distribution in Plant Amino Acid Sequence, S-S Bridge Arrangement and Distribution in Plant Tissues of Thionins from Viscum album *. Biol. Chem. 1997, 378, 989–996. [Google Scholar]
- Kishi-Kaboshi, M.; Okada, K.; Kurimoto, L.; Murakami, S.; Umezawa, T.; Shibuya, N.; Yamane, H.; Miyao, A.; Takatsuji, H.; Takahashi, A.; et al. A rice fungal MAMP-responsive MAPK cascade regulates metabolic flow to antimicrobial metabolite synthesis. Plant J. 2010, 63, 599–612. [Google Scholar] [CrossRef] [PubMed] [Green Version]
- Offor, B.C.; Dubery, I.A.; Piater, L.A. Prospects of gene knockouts in the functional study of mamp-triggered immunity: A review. Int. J. Mol. Sci. 2020, 21, 2540. [Google Scholar] [CrossRef] [PubMed] [Green Version]
- Slavokhotova, A.A.; Rogozhin, E.A. Defense Peptides From the α-Hairpinin Family Are Components of Plant Innate Immunity. Front. Plant Sci. 2020, 11, 465. [Google Scholar] [CrossRef] [PubMed]
- Sousa, D.A.; Porto, W.F.; Silva, M.Z.; Da Silva, T.R.; Franco, O.L. Influence of cysteine and tryptophan substitution on DNA-binding activity on maize α-hairpinin antimicrobial peptide. Molecules 2016, 21, 1062. [Google Scholar] [CrossRef] [Green Version]
- Nam, J.; Yun, H.; Rajasekaran, G.; Kumar, S.D.; Kim, J.I.; Min, H.J.; Shin, S.Y.; Lee, C.W. Structural and Functional Assessment of mBjAMP1, an Antimicrobial Peptide from Branchiostoma japonicum, Revealed a Novel α-Hairpinin-like Scaffold with Membrane Permeable and DNA Binding Activity. J. Med. Chem. 2018, 61, 11101–11113. [Google Scholar] [CrossRef] [PubMed]
- Rogozhin, E.A.; Ryazantsev, D.Y.; Grishin, E.V.; Egorov, T.A.; Zavriev, S.K. Defense peptides from barnyard grass (Echinochloa crusgalli L.) seeds. Peptides 2012, 38, 33–40. [Google Scholar] [CrossRef] [PubMed]
- Cui, X.; Du, J.; Li, J.; Wang, Z. Inhibitory Site of α-Hairpinin Peptide From Tartary Buckwheat Has No Effect on Its Antimicrobial Activities. Acta Biochim. Biophys. Sin. (Shanghai) 2018, 50, 408–416. [Google Scholar] [CrossRef] [Green Version]
- Molina, A.; Goy, P.A.; Fraile, A.; Sánchez-Monge, R.; García-Olmedo, F. Inhibition of bacterial and fungal plant pathogens by thionins of types I and II. Plant Sci. 1993, 92, 169–177. [Google Scholar] [CrossRef] [Green Version]
- Bohlmann, H.; Clausen, S.; Behnke, S.; Giese, H.; Hiller, C.; Reimann-Philipp, U.; Schrader, G.; Barkholt, V.; Apel, K. Leaf-specific thionins of barley-a novel class of cell wall proteins toxic to plant-pathogenic fungi and possibly involved in the defence mechanism of plants. EMBO J. 1988, 7, 1559–1565. [Google Scholar] [CrossRef] [PubMed]
- Giudici, M.; Antonio Poveda, J.; Molina, M.L.; De La Canal, L.; González-Ros, J.M.; Pfüller, K.; Pfüller, U.; Villalaín, J. Antifungal effects and mechanism of action of viscotoxin A3. FEBS J. 2006, 273, 72–83. [Google Scholar] [CrossRef]
- Büssing, A.; Stein, G.M.; Wagner, M.; Wagner, B.; Schaller, G.; Pfüller, U.; Schietzel, M. Accidental cell death and generation of reactive oxygen intermediates in human lymphocytes induced by thionins from Viscum album L. Eur. J. Biochem. 1999, 262, 79–87. [Google Scholar] [CrossRef] [PubMed]
- Thevissen, K.; Terras, F.R.G.; Broekaert, W.F. Permeabilization of fungal membranes by plant defensins inhibits fungal growth. Appl. Environ. Microbiol. 1999, 65, 5451–5458. [Google Scholar] [CrossRef] [PubMed] [Green Version]
- Parisi, K.; Shafee, T.M.A.; Quimbar, P.; van der Weerden, N.L.; Bleackley, M.R.; Anderson, M.A. The evolution, function and mechanisms of action for plant defensins. Semin. Cell Dev. Biol. 2019, 88, 107–118. [Google Scholar] [CrossRef]
- Evett, G.E.; Donaldson, D.M.; Vernon, L.P. Biological properties of Pyrularia thionin prepared from nuts of Pyrularia pubera. Toxicon 1986, 24, 622–625. [Google Scholar] [CrossRef]
- Carrasco, L.; Vázqes, D.; Hernández-Lucas, C.; Carbonero, P.; García-Olmedo, F. Thionins: Plant Peptides that Modify Membrane Permeability in Cultured Mammalian Cells. Eur. J. Biochem. 1981, 116, 185–189. [Google Scholar] [CrossRef] [PubMed] [Green Version]
- Hughes, P.; Dennis, E.; Whitecross, M.; Llewellyn, D.; Gage, P. The cytotoxic plant protein, β-purothionin, forms ion channels in lipid membranes. J. Biol. Chem. 2000, 275, 823–827. [Google Scholar] [CrossRef] [Green Version]
- Kul’Ko, A.B.; Kisil, O.V.; Sadykova, V.S.; Mikhailov, V.F.; Vasilieva, I.M.; Shulenina, L.V.; Zasukhina, G.D.; Rogozhin, E.A. Investigation of thionins from black cumin (Nigella sativa L.) seeds showing cytotoxic, regulatory and antifungal activity. Antibiot. Khimioterapiya 2016, 61, 8–16. [Google Scholar]
- Li, S.; Gullbo, J.; Lindholm, P.; Larsson, R.; Thunberg, E.; Samuelsson, G.; Bohlin, L. DNA-binding domain from the mistletoe Phoradendron liga. Biochem. J. 2002, 413, 405–413. [Google Scholar] [CrossRef] [Green Version]
- Woynarowski, J.M.; Konopa, J. Interaction between dna and viscotoxins cytotoxic basic polypeptides from Viscum album L. Hoppe Seylers Z. Physiol. Chem. 1980, 361, 1535–1546. [Google Scholar] [CrossRef] [PubMed]
- OITA, S. Degradation of the antimicrobial peptide alpha-thionin by Aspergillus proteases. J. Brew. Soc. JAPAN 2000, 95, 776–779. [Google Scholar] [CrossRef]
- Vasilchenko, A.S.; Yuryev, M.; Ryazantsev, D.Y.; Zavriev, S.K.; Feofanov, A.V.; Grishin, E.V.; Rogozhin, E.A. Studying of cellular interaction of hairpin-like peptide EcAMP1 from barnyard grass (Echinochloa crusgalli L.) seeds with plant pathogenic fungus Fusarium solani using microscopy techniques. Scanning 2016, 38, 591–598. [Google Scholar] [CrossRef] [PubMed] [Green Version]
- Alferova, V.A.; Novikov, R.A.; Bychkova, O.P.; Rogozhin, E.A.; Shuvalov, M.V.; Prokhorenko, I.A.; Sadykova, V.S.; Kulko, A.B.; Dezhenkova, L.G.; Stepashkina, E.A.; et al. Astolides A and B, antifungal and cytotoxic naphthoquinone-derived polyol macrolactones from Streptomyces hygroscopicus. Tetrahedron 2018, 74, 7442–7449. [Google Scholar] [CrossRef]
- Arendrup, M.C.; Cuenca-Estrella, M.; Lass-Flörl, C.; Hope, W.; Arendrup, M.C.; Hope, W.W.; Flörl, C.; Cuenca-Estrella, M.; Arikan, S.; Barchiesi, F.; et al. EUCAST Technical Note on Aspergillus and amphotericin B, itraconazole, and posaconazole. Clin. Microbiol. Infect. 2012, 18. [Google Scholar] [CrossRef] [PubMed] [Green Version]
- Shckorbatov, Y.G.; Pasiuga, V.N.; Kolchigin, N.N.; Grabina, V.A.; Batrakov, D.O.; Kalashnikov, V.V.; Ivanchenko, D.D.; Bykov, V.N. The influence of differently polarised microwave radiation on chromatin in human cells. Int. J. Radiat. Biol. 2009, 85, 322–329. [Google Scholar] [CrossRef] [PubMed]

| Fraction | Peptide Name | Retention Time min | Molecular Mass (Average) Da | N-Terminal Amino Acid Sequence |
|---|---|---|---|---|
| 1 | NsW5 | 25.2 | 5161.6 | KSCCKNTLGRNCYNTCRFMK… |
| 2 | NsW6 | 27.3 | 5161.6 | KSCCKNTLGRNCYNTCRFMK… |
| 3 | NsW1 | 25.2 | 5063.4 | KSCCKNTLGRNCYNTCRFMK… |
| 4 | NsW4 | 26.1 | 5041.2 | KSCCKNTLGRNCYNTCRFIK… |
| 5 | NsW3 | 26.7 | 5227.3 | KSCCKNTLGRNCYNTCRFIK… |
| 6 | NsW2 | 27.3 | 5141.5 | KSCCKNTLGRNCYNTCRFIK… |
| 7 | NsW7 | 28.3 | 5308.4 | KSCCKNTLGRNCYNTCRFMK… |
| 8 | NsW8 | 29.4 | 5271.2 | GSCCKNTLGRNCYNTCRFMK… |
| 9 | NsW9 | 30.7 | 5169.6 | GSCCKNTLGRNCYNTCRFIK… |
| Fungal Strains | Growth Inhibition Zone, mm | |||
|---|---|---|---|---|
| NsW1 | NsW2 | NsW4 | Amphotericin B | |
| A. flavus 3K | 12.2 ± 0.4 | 11.0 ± 0.3 | 13.1 ± 0.3 | 13.49 ± 1.0 |
| A. terreus 3K | 0 | 0 | 0 | 0 |
| A. fumigatus 2K | 7.5 ± 0.1 | 11.1± 0.7 | 10.2 ± 0.6 | 16.8 ± 0.7 |
| A. oryzae 1K | 8.5 ± 0.7 | 12.7 ± 0.1 | 11.9 ± 0.8 | 17.5 ± 0.9 |
| Fungi | Growth Inhibition Zone, mm | |||
|---|---|---|---|---|
| NsW2 | Amphotericin B | Nystatin | Fluconazole | |
| Non-clinical strains | ||||
| A. flavus 3K | 11.0 ± 0.3 | 13.5± 1.0 | - | - |
| A. fumigatus 2K * | 11.1± 0.7 | 16.8 ± 0.7 | - | - |
| A. oryzae 1K | 12.7 ± 0.1 | 17.5 ± 0.9 | - | - |
| A. terreus 3K | 0 | 0 | - | - |
| Clinical isolates | ||||
| A. fumigatus 163m * | 11 ± 0.3 | - | 22 ± 0.5 | 0 |
| A. flavus 905n | 11.5 ± 0.5 | - | 23 ± 0.3 | 0 |
| A. terreus 1133 | 8.5 ± 0.3 | - | 15 ± 0.7 | 0 |
| Yeast Strain | Growth Inhibition Zone, mm | |
|---|---|---|
| NsW2 | AmB | |
| S. cerevisiae 77S | 12.5 ± 1 | 18 ± 0.3 |
| Cr. laurentii 801M | 11.5 ± 0.1 | 10 ± 0.6 |
| C. krusei 1447N | 7.6 ± 0.3 | 8.2 ± 0.8 |
| C. glabrata 1402m | 0 | 8 ± 0.3 |
| Compound | IC50, µM | ||
|---|---|---|---|
| HCT-116 | B16 | HPF | |
| NsW2 | 0.30 ± 0.04 | 0.20 ± 0.03 | 0.55 ± 0.07 |
| Doxorubicin | 0.15 ± 0.02 | 1.20 ± 0.17 | 0.45 ± 0.06 |
Publisher’s Note: MDPI stays neutral with regard to jurisdictional claims in published maps and institutional affiliations. |
© 2021 by the authors. Licensee MDPI, Basel, Switzerland. This article is an open access article distributed under the terms and conditions of the Creative Commons Attribution (CC BY) license (http://creativecommons.org/licenses/by/4.0/).
Share and Cite
Barashkova, A.S.; Sadykova, V.S.; Salo, V.A.; Zavriev, S.K.; Rogozhin, E.A. Nigellothionins from Black Cumin (Nigella sativa L.) Seeds Demonstrate Strong Antifungal and Cytotoxic Activity. Antibiotics 2021, 10, 166. https://doi.org/10.3390/antibiotics10020166
Barashkova AS, Sadykova VS, Salo VA, Zavriev SK, Rogozhin EA. Nigellothionins from Black Cumin (Nigella sativa L.) Seeds Demonstrate Strong Antifungal and Cytotoxic Activity. Antibiotics. 2021; 10(2):166. https://doi.org/10.3390/antibiotics10020166
Chicago/Turabian StyleBarashkova, Anna S., Vera S. Sadykova, Victoria A. Salo, Sergey K. Zavriev, and Eugene A. Rogozhin. 2021. "Nigellothionins from Black Cumin (Nigella sativa L.) Seeds Demonstrate Strong Antifungal and Cytotoxic Activity" Antibiotics 10, no. 2: 166. https://doi.org/10.3390/antibiotics10020166
APA StyleBarashkova, A. S., Sadykova, V. S., Salo, V. A., Zavriev, S. K., & Rogozhin, E. A. (2021). Nigellothionins from Black Cumin (Nigella sativa L.) Seeds Demonstrate Strong Antifungal and Cytotoxic Activity. Antibiotics, 10(2), 166. https://doi.org/10.3390/antibiotics10020166






